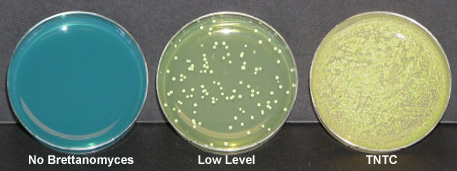

This is BRETT MICROBIOLOGY MADE SIMPLE, no Bunsen burners and loops - and
minimal sterile technique required. Just use the dropper to apply a few
drops of wine (bottom sample is still preferred), add the
sterile glass beads, shake briefly to spread the wine (and discard the
beads), place the lid on the petri dish and set aside. Read results after
a few days.
This pre-poured Brett Agar plate is ideal; the formulation suppresses
other yeast strains and encourages the grown of Brett. Results can be seen
in as early as 4-days, with final results in 12-days for the slowest
growing strains of Brett.
| |
|
Easy Blue
Brettanomyces Test Kit
Item#: W1001C60
Our Price:
12 tests For $249
32 tests For $399
Main Features »
This is BRETT
MICROBIOLOGY MADE SIMPLE, no Bunsen burners and loops -f
and
minimal sterile technique required. Just use the
dropper to apply a few
drops of wine (bottom sample
is still preferred, of course), add the
sterile glass
beads, shake briefly to spread the wine (and discard the
beads), place the lid on the petri dish and put in
supplied incubation bag.
Complete
Directions:
Intended Use
For the detection and
cell counts of Dekkera/Brettanomyces in juice or wine
samples. Brettanomyces tends to settle on the bottom.
Sample from the bottom or mix before taking sample.
Remove Parafilm from edges of each plate before you
start.
Procedure
· Apply 5 drops (50uL) in
circular pattern directly to agar using supplied dropper
-- or
· Filter Sample through a 0.45u or 0.22u pore
size membrane and place the filter on the surface of the
agar (avoid trapping air bubbles between membrane and
agar.
· Add 1 tube worth of supplied glass beads,
cover plate.
· With plate flat on the table,
slide/shake plate back and forth about 10 times.
·
Remove top and invert plate over waste container to
dispose of beads. Cover plate. Place in supplied
incubation bag. Seal bag.
· Incubate for several days
· Examine the plates after several days of incubation;
look/smell for colour change and phenolic odor, after
4-12 days look for colonies. Record the number of
colonies
Interpretation
This media is very
selective for Brettanomyces and is enriched to assure
relatively fast growth of this slow-growing organism.
Consider being positive if:
1. Colony growth is
detected between 4 - 12 days. Colony appearance is
cheesy, whitish-yellow
2. The agar colour change from
blue to yellow can occur within 4-12 days.
3. A
phenolic medicinal or leathery odor is detected when
opening the plate. Can occur in 48 hours or longer.
Suggested: Compare odor to Brett sensory set (sold
separately).
If single colonies develop, multiply
by 20 to get colony forming units (CFU) per ml. If color
change and development of phenolic odor is rapid and a
haze develops over the entire plate, your sample is TNTC
(To Numerous To Count) and contains over 10,000 CFU/ml.
Brett phenolic metabolites taint the wine when Brett is
at high concentrations. If you get a TNTC result:
1.
Immediately filter or otherwise sanitize the wine
2.
Repeat the assay with serial 1:10 dilutions to determine
exact cell concentration and confirm the extent of Brett
contamination.
3. Retest after remediation to make
sure effective.
Precautions
To avoid cross
contamination of the winery environment, it is
recommended that after the test is complete 10% bleach
or 70% alcohol is applied to the plate and beads prior
to disposal.
Minimize the time that the top is
off from the dish. Work in a draft free environment.
Avoid directly touching the agar medium.
Storage
Store refrigerated between 2-8ºC
Shelf life: 4 months with refrigeration, 2 months without refrigeration
Lebrun Labs LLC
3301 E. Miraloma Ave
Suite 194, Anaheim, CA 92806
Office (949) 246-0339, Lab (714) 345-4689, Fax 844 272-9854
sales@lebrunlabs.com
Identification and Control of Brettanomycesin the Vineyard and Winery
|